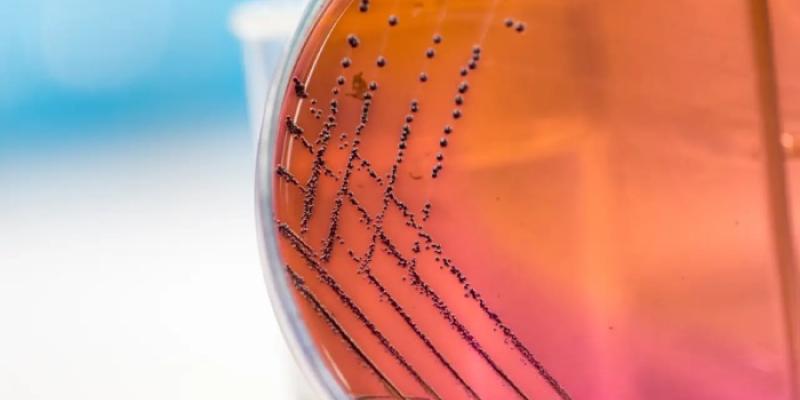
Antibióticos

Lectura fácil
El aumento de bacterias resistentes a varios antibióticos ya no es solo una preocupación futura, sino una amenaza creciente para la salud pública mundial. Científicos de la Universidad del Norte de Arizona han señalado que no es cuestión de si ocurrirá, sino de cuándo, y que podría provocar un gran aumento en las muertes por infecciones.
El creciente riesgo de resistencia a antibióticos
Un nuevo estudio, publicado este diciembre en Communications Medicine, presenta una perspectiva preocupante: conforme el uso de antibióticos crece a nivel mundial, las bacterias también incrementan su habilidad para desarrollar resistencia a estos medicamentos.
Este fenómeno, denominado resistencia a múltiples fármacos, constituye una amenaza importante. Sin embargo, lo que resulta aún más alarmante es la aparición de patógenos que son resistentes a todos los antibióticos disponibles, lo que se conoce como panresistencia.
Según Benjamin Koch, autor principal del estudio y científico del Centro de Ciencias de Ecosistemas y Sociedad (Ecoss), esta evolución podría generar un impacto sanitario de una magnitud sin precedentes.
Junto a Koch, Bruce Hungate, director de Ecoss, y otros expertos de instituciones como la Universidad de Minnesota y la Escuela de Salud Pública del Instituto Milken, desarrollaron un modelo predictivo para evaluar las posibles consecuencias de esta amenaza. Los resultados son preocupantes: una cepa hipotética de E. coli panresistente podría aumentar las muertes por sepsis entre 18 y 46 veces en solo cinco años después de su aparición.
Modelos del futuro
La amenaza de la panresistencia Aunque la cepa panresistente modelada aún no ha surgido, los investigadores subrayan que, dada la rapidez con la que las bacterias están evolucionando, es solo cuestión de tiempo. Esto podría suceder en un año o dentro de varias décadas, pero la imprecisión de las predicciones no disminuye la urgencia del problema.
La panresistencia representa un desafío singular porque afecta de manera indiscriminada a todas las poblaciones. Aunque los países con mayores ingresos suelen disponer de sistemas de salud más robustos y una mayor variedad de tratamientos, una vez que las bacterias desarrollan panresistencia, esas ventajas dejan de ser efectivas.
La lucha por la supervivencia
A pesar de la seriedad de la amenaza, aún existen acciones que pueden disminuir sus efectos. Gobiernos, industrias y ciudadanos juegan un papel crucial en frenar el avance de la resistencia a cualquier antibiótico. Es fundamental implementar políticas que regulen el uso responsable de antibióticos tanto en la medicina como en la producción de alimentos, así como fomentar el uso de tecnologías que permitan rastrear la aparición y propagación de la resistencia.
Consumir algún antibiótico solo con receta médica, apoyar políticas que promuevan el desarrollo de nuevos antibióticos y exigir una gestión más responsable son algunas de las acciones individuales.
Hacia un futuro sostenible
El mensaje de los autores es rotundo: para frenar las fuerzas que impulsan la evolución y expansión de patógenos resistentes, es necesario adoptar estrategias globales que impliquen una mejor gestión de los antibióticos en la medicina humana y veterinaria, así como en la producción alimentaria.
A pesar de ello, la pregunta sigue siendo la misma: ¿actuaremos a tiempo para detener esta amenaza inminente o dejaremos que nuestra negligencia nos conduzca a una crisis sanitaria de dimensiones épicas? La respuesta depende de nosotros.



Añadir nuevo comentario